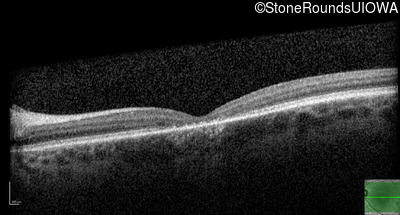
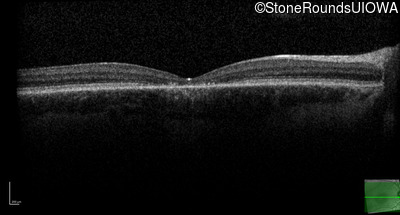
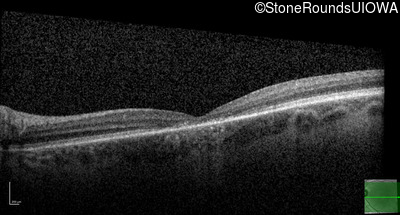
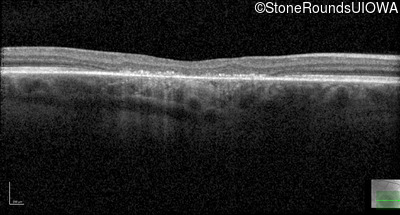
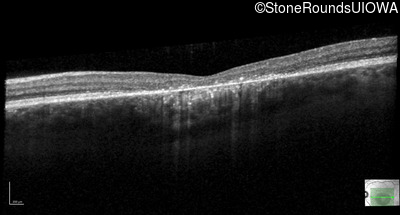
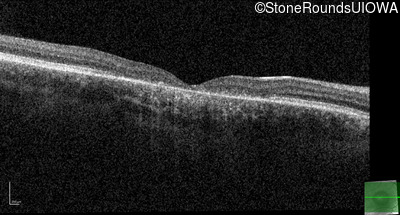
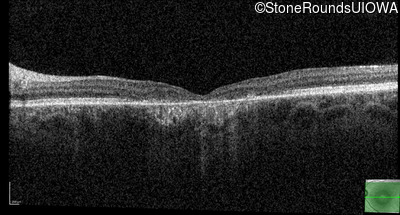
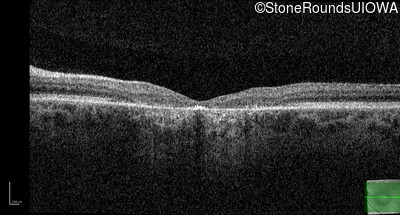

Case
SR1895
Student Mode
AD Cone and Cone Rod Dystrophy (IA1bii)
Male
Male
Hidden
SR1895
Student Mode
AD Cone and Cone Rod Dystrophy (IA1bii)
Male
Male
History
This 17 year old male was correctable to 20/30 OU when he got his first glasses at age 5. At age 13 his best corrected vision was 20/40 OU. He feels that his color vision has always been poor.
| Age at visit: 17 years |
| Age at visit: 17 years (Visit 2) |
| Age at visit: 21 years |
| Age at visit: 23 years |
Diagnosis & molecular findings
| Disease | Gene | Allele 1 variant(s) | Allele 2 variant(s) | Inheritance mode |
|---|---|---|---|---|
| AD Cone and Cone Rod Dystrophy | GUCY2D | Arg838His CGC>CAC | AD |
Disease:
Gene:
Allele 1:
Arg838His CGC>CAC
Allele 2:
Inheritance:
AD